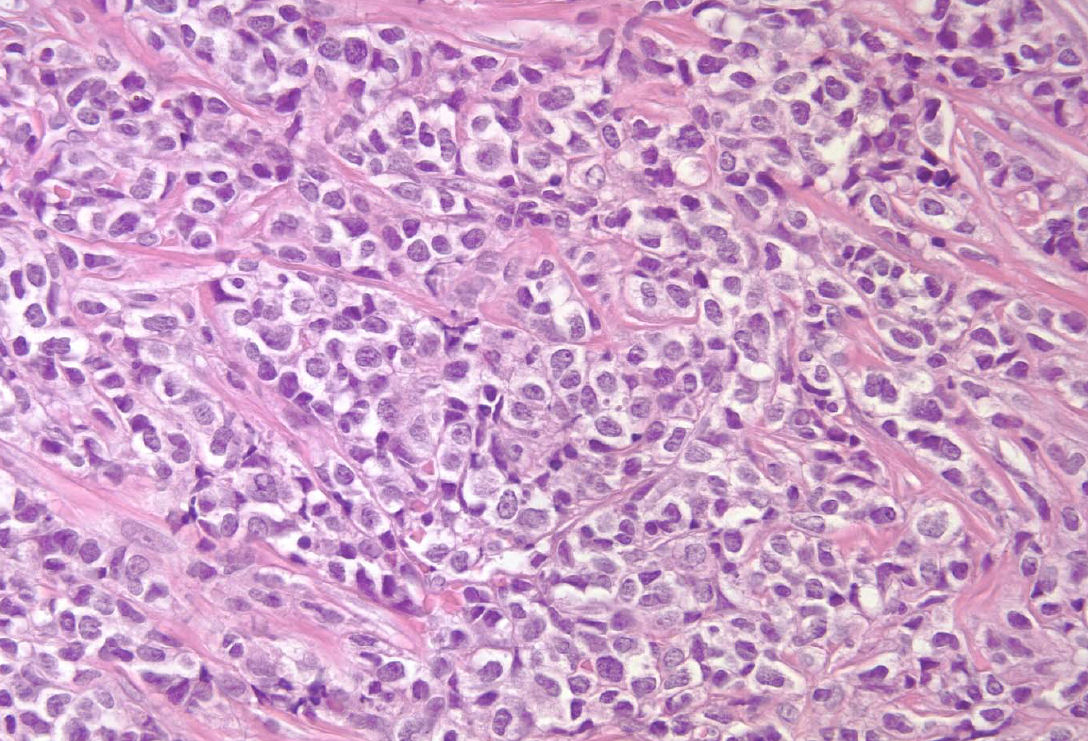

Em aproximadamente 5% a 10% dos pacientes com leucemia aguda têm marcadores morfológicos, citoquímicos e imunofenotípicos demonstrando duas linhagens diferentes nos blastos: a linhagem mielóide e a linhagem linfóide. Este subtipo de leucemia é denominado leucemia bifenotípica.
Os marcadores estão expressos nos blastos geralmente em mais de uma linhagem, e a doença pode ter início nas células mais indiferenciadas, isto é, antes de se diferenciar em linfóide ou mielóide. Se estes casos representam a expressão do gene ou a transformação aberrante de uma célula mãe pluripotente é desconhecida.
As leucemias bifenotípicas parecem ser mais comuns nos pacientes com síndrome mielodisplásica prévia, leucemias secundárias, leucemias associados a translocação (11q23) e o cromossomo de Filadélfia (Ph).
Nenhuma recomendação específica do tratamento foi estabelecida para estes pacientes, mas a maioria dos oncologistas utiliza um protocolo híbrido para leucemia mielóide na indução e linfóide na manutenção com o intuito de destruir a maioria dos clones malignos.